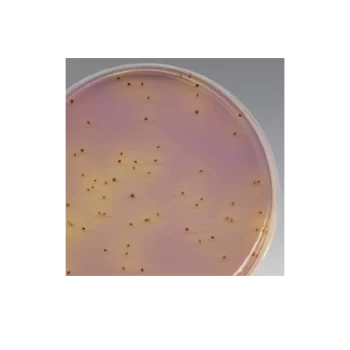

Showing 109–117 of 337 results
HBSS, no calcium, no magnesium, 100ML / HBSS, sin calcio, sin magnesio
S/ 0.00
[SKU: 14170120]
La solución salina equilibrada (HBSS) de Hanks se utiliza para una variedad de aplicaciones de cultivo celular, como lavar células antes de la disociación, transportar células o muestras de tejido, diluir células para contar y preparar reactivos.
Hi-Di Formamide, 25 ml / Formamida Hi-Di
S/ 0.00
[SKU: 4311320]
La configuración más pequeña (5 ml) minimiza el número de ciclos de congelación/descongelación en comparación con el frasco de 25 ml más grande.
K-F Streptococcus Agar (Dehydrated) / Agar KF Streptococcus (deshidratado)
S/ 0.00
[SKU: CM0701B]
Aísle y enumere los enterococos en alimentos, leche, agua y muestras ambientales con el agar selectivo para estreptococos Thermo Scientific™ Oxoid™ KF (deshidratado) mediante el método de filtración con membrana o placa de vertido.
KaryoMAX™ Colcemid Solution in PBS / Solución KaryoMAX Colcemid en PBS
S/ 0.00
[SKU: 15212012]
La solución Gibco™ KaryoMAX™ Colcemid™ en PBS es una solución de N-desacetil-N-metilocolchicina (Colcemid™) de 10 μg/ml elaborada en solución salina tamponada con fosfato (PBS).
Kit de 1 paso TaqMan™ RNA-to-C T ™ / TaqMan™ RNA-to-CT™ 1-Step Kit
S/ 0.00
[SKU: 4392938]
El kit de 1 paso TaqMan RNA-to-CT de Applied Biosystems ofrece una cuantificación consistente del objetivo de ARN para una amplia variedad de ensayos y está validado con la biblioteca completa de Applied Biosystems de ensayos de expresión genética TaqMan.
Kit de aislamiento de ácidos nucleicos virales/patógenos MagMAX™ / MagMAX™ Viral/Pathogen Nucleic Acid Isolation Kit
S/ 0.00
[SKU: A42352]
El kit de aislamiento de ácidos nucleicos virales/patógenos MagMAX está diseñado para recuperar ARN y ADN de virus y bacterias gramnegativas en muestras como sangre, hisopos, orina y medios de transporte viral (VTM).
Kit de aislamiento de ADN vegetal MagMAX™ / MagMAX™ Plant DNA Isolation Kit
S/ 0.00
[SKU: A47156]
El kit de aislamiento de ADN vegetal MagMAX™ está diseñado para la purificación manual o automatizada de alto rendimiento de ADN de una amplia variedad de especies de plantas.
Kit de aislamiento de ARN vegetal MagMAX
S/ 0.00
[SKU: A47152]
El kit de aislamiento de ARN vegetal MagMAX está diseñado para la extracción rápida de ARN de alta pureza adecuado para todas las aplicaciones de biología molecular convencionales, entre las que se incluyen: RT-PCR, RT-qPCR, Northern blotting, ensayo de protección de nucleasas
Kit de amplificación por PCR GlobalFiler™ / GlobalFiler™ PCR Amplification Kit
S/ 0.00
[SKU: 4476135]
El kit de amplificación de PCR GlobalFiler es el primer kit STR de 24 locus y 6 tintes que combina la máxima compatibilidad con los estándares de loci de bases de datos globales, con un tiempo de amplificación drásticamente reducido y un poder de discriminación superior, lo que ayuda a que los laboratorios de ADN forenses de todo el mundo maximicen la recuperación de información y mejoren la información.